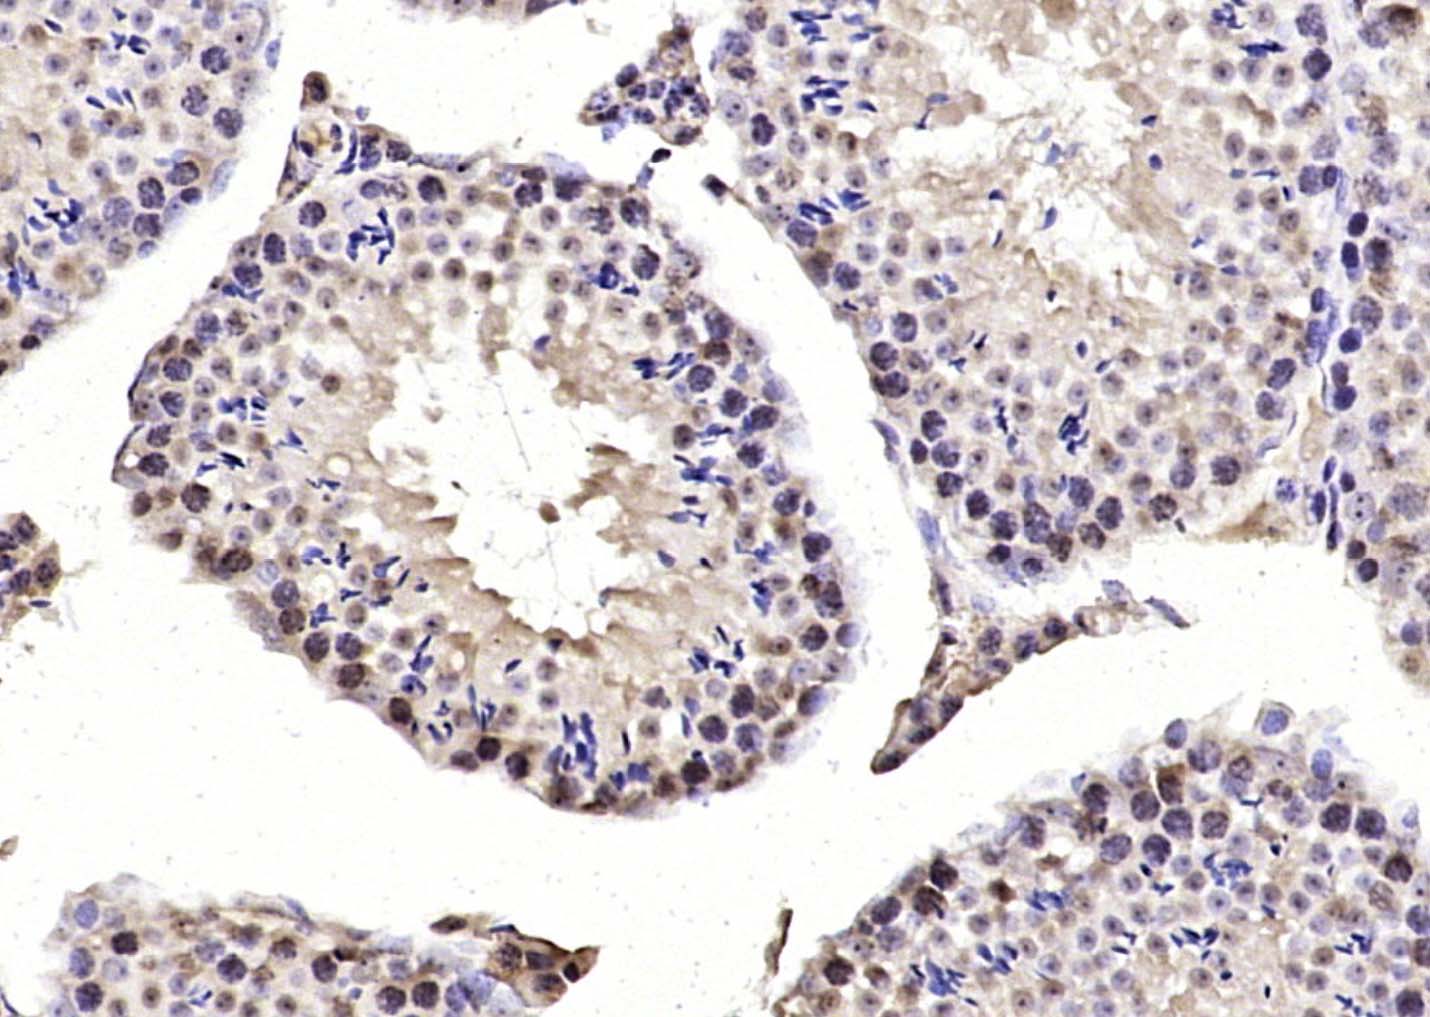
MIS12 Rabbit pAb(bs-7713R)-50u

相关产品推荐更多 >

BRN3B Rabbit pAb(bs-6985R)-50ul/100ul/200ul
¥1180
CK5+CK6 Rabbit pAb, PE-Cy5.5 conjugated(bs-20824R-PE-Cy5.5)-100ul
¥2980
NFKB p65 Rabbit pAb, PerCP-Cy7 conjugated(bs-0465R-PerCP-Cy7)-100ul
¥2980
Ricin A chain Rabbit pAb, AP conjugated(bs-7140R-AP)-100ul
¥2980
RGS5 Rabbit pAb, Cy7 conjugated(bs-2794R-Cy7)-100ul
¥2980
万千商家帮你免费找货
0 人在求购买到急需产品
- 详细信息
- 文献和实验
- 技术资料
- 应用范围:
产品信息以Bioss网站为准
- 规格:
50ul/100ul/200ul
| 规格: | 50ul | 产品价格: | ¥1180.0 |
|---|---|---|---|
| 规格: | 100ul | 产品价格: | ¥1980.0 |
| 规格: | 200ul | 产品价格: | ¥2800.0 |
| 产品编号 | bs-7713R |
| 英文名称 | MIS12 Rabbit pAb |
| 中文名称 | 染色体及有丝分裂蛋白MIS12抗体 |
| 英文别名 | hMIS12; homolog of yeast Mis12; KNTC2AP; MIND kinetochore complex component, homolog(yeast); MIS12 homolog(yeast); MIS12 homolog; MIS12 MIND kinetochore complex component homolog(yeast); MTW 1; MTW1; Protein MIS12 homolog; MIS12_HUMAN. |
| 产品应用 | IHC-P=1:100-500, IHC-F=1:100-500, IF=1:100-500 Not yet tested in other applications. |
| 交叉反应 | Mouse (Human, Rat, Dog, Cow, Horse, Sheep) |
| 抗体来源 | Rabbit |
| 免疫原 | KLH conjugated synthetic peptide derived from human MIS12 |
| 亚型 | IgG |
| 性状 | Liquid |
| 纯化方法 | affinity purified by Protein A |
| 克隆类型 | Polyclonal |
| 理论分子量 | 24 kDa |
| 浓度 | 1mg/ml |
| 储存液 | 0.01M TBS (pH7.4) with 1% BSA, 0.02% Proclin300 and 50% Glycerol. |
| 研究领域 | Cell Biology > Cell Cycle > Cell Division > Centromere Epigenetics and Nuclear Signaling > Cell cycle > Chromosome Structure > Centromere Epigenetics and Nuclear Signaling > Chromosome Structure > Centromeres |
| 亚基 | Component of the MIS12 complex composed of MIS12, DSN1, NSL1 and PMF1. Also interacts with CASC5, CBX3, CBX5, NDC80 and ZWINT. |
| 亚细胞定位 | Nucleus. Chromosome, centromere, kinetochore. Note=Associated with the kinetochore. |
| 相似性 | Belongs to the mis12 family. |
| 功能 | Part of the MIS12 complex which is required for normal chromosome alignment and segregation and for kinetochore formation during mitosis. |
| 保存条件 | Shipped at 4℃. Store at -20℃ for one year. Avoid repeated freeze/thaw cycles. |
| 注意事项 | This product as supplied is intended for research use only, not for use in human, therapeutic or diagnostic applications. |
| 背景资料 | MIS12 is part of a complex that plays an essential role in chromosome segregation in vertebrates and contributes to mitotic kinetochore assembly. |
| 应用 | 推荐稀释比例 |
| {IHC-P} | {1:100-500} |
| {IHC-F} | {1:100-500} |
| {IF} | {1:100-500} |
风险提示:丁香通仅作为第三方平台,为商家信息发布提供平台空间。用户咨询产品时请注意保护个人信息及财产安全,合理判断,谨慎选购商品,商家和用户对交易行为负责。对于医疗器械类产品,请先查证核实企业经营资质和医疗器械产品注册证情况。
文献和实验[IF={{ 9.6 }}] {Ogasawara, Shinyu, et al. "Cathepsin K activity controls cardiotoxin‐induced skeletal muscle repair in mice." Journal of Cachexia, Sarcopenia and Muscle (2017).} {IHC} {="Mouse"}
[IF={{ 5.443 }}] {Goto Hiroki. et al. Proliferin-1 Ameliorates Cardiotoxin-Related Skeletal Muscle Repair in Mice. Stem Cells Int. 2021;2021:9202990} {IF} {Mouse}
[IF={{ 12.511 }}] {Ogasawara et al. Cathepsin K activity controls cardiotoxin-induced skeletal muscle repair in mice. (2018) J.Cachexia.Sarcopenia.Muscle. 9:160-175} {IHC} {Mouse}
= NAL), appears to form upon oxidative cyclization of the nonfluorescent 2:1 lysine-HNE Michael adduct-Schiff base cross-link (Scheme 1). Polyclonal antibody (PAb) to the NAL-HNE fluorophore was raised in rabbit and found to be highly specific
GE Healthcare Benzamidine Sepharose™ 6B is p-aminobenzamidine covalently attached to Sepharose 6B by the epoxy coupling method. p-Aminobenzamidine (PAB), is a synthetic inhibitor of trypsin-like serine protease. Trypsin and trypsin
Nucleic Acid Programmable Protein Arrays: Versatile Tools for Array‐Based Functional Protein Studies
.g., Sigma) 50 mg/ml bis‐sulfosuccinimdylsuberate (BS3 ;Pierce, cat. no. PI 21580) in dimethylsulfoxide (DMSO) 5 mg/ml
技术资料暂无技术资料 索取技术资料






